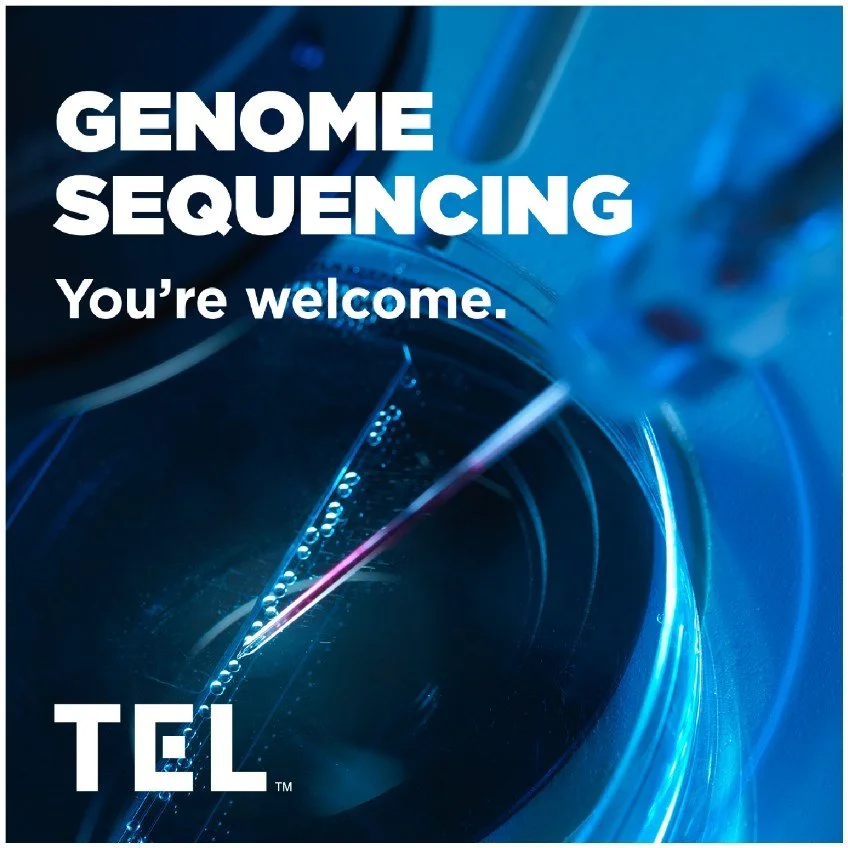

Tokyo Electron (TEL)
Social Media Campaigns
Tokyo Electron is the third-largest semiconductor manufacturing company in the world, but good luck finding an everyday Joe that knows who they are. The problem doesn’t lie in their sales, it lies in the fact that 65% of their workforce is set to retire in the next three years. The majority of the general public doesn’t even know the company exists, much less that they dominate an entire global industry that touches every human on Earth. Their social media marketing efforts are focused on attracting talented people by showing them in layman's terms what TEL is capable of doing.
campaign: “You’re welcome” | concept, art direction, copy
Chosen by the SEMI foundation as an industry-wide campaign to run in an effort to garner the attention of the up-and-coming generation of workers in the field.
campaign: “from tel to your _” | concept, copy, design
You’ve never heard of them, but somehow they’re involved in every aspect of your world; With a B2C mindset, this campaign told the end customer how we’re relevant in today’s world.
Military & U.S. Holidays (after)
Original content highlighting military holidays in the U.S. lacked any kind of unity. A strategy was devised to use only secondary brand colors, and stay away from photography in an attempt to bring cohesion to military-related social media posts.